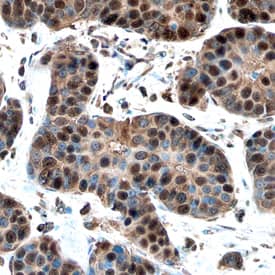
Cyclin E1 antibody in Human Breast by Immunohistochemistry (IHC-P).

Human Cyclin E1 Antibody
R&D Systems, part of Bio-Techne | Catalog # AF6810


Key Product Details
Species Reactivity
Validated:
Cited:
Applications
Validated:
Cited:
Label
Antibody Source
Product Specifications
Immunogen
Met16-Lys143
Accession # P24864
Specificity
Clonality
Host
Isotype
Scientific Data Images for Human Cyclin E1 Antibody
Detection of Human Cyclin E1 by Western Blot.
Western blot shows lysates of K562 human chronic myelogenous leukemia cell line and HEK293 human embryonic kidney cell line. Gels were loaded with 25 µg of cytoplasmic (Cyto) and 25 µg of nuclear (Nuc) extracts. PVDF membrane was probed with 1 µg/mL of Sheep Anti-Human Cyclin E1 Antigen Affinity-purified Polyclonal Antibody (Catalog # AF6810) followed by HRP-conjugated Anti-Sheep IgG Secondary Antibody (HAF016). Specific bands were detected for Cyclin E1 at approximately 50 - 60 kDa (as indicated). This experiment was conducted under reducing conditions and using Immunoblot Buffer Group 8.Cyclin E1 in Human Breast.
Cyclin E1 was detected in immersion fixed paraffin-embedded sections of human breast using Sheep Anti-Human Cyclin E1 Antigen Affinity-purified Polyclonal Antibody (Catalog # AF6810) at 10 µg/mL overnight at 4 °C. Before incubation with the primary antibody, tissue was subjected to heat-induced epitope retrieval using Antigen Retrieval Reagent-Basic (CTS013). Tissue was stained using the Anti-Sheep HRP-DAB Cell & Tissue Staining Kit (brown CTS019) and counterstained with hematoxylin (blue). Specific staining was localized to nuclei. View our protocol for Chromogenic IHC Staining of Paraffin-embedded Tissue Sections.Detection of Human Cyclin E1 by Simple WesternTM.
Simple Western lane view shows lysates of HepG2 human hepatocellular carcinoma cell line, loaded at 0.2 mg/mL. A specific band was detected for Cyclin E1 at approximately 53 kDa (as indicated) using 10 µg/mL of Sheep Anti-Human Cyclin E1 Antigen Affinity-purified Polyclonal Antibody (Catalog # AF6810) followed by 1:50 dilution of HRP-conjugated Anti-Sheep IgG Secondary Antibody (Catalog # HAF016). This experiment was conducted under reducing conditions and using the 12-230 kDa separation system.Applications for Human Cyclin E1 Antibody
Immunohistochemistry
Sample: Immersion fixed paraffin-embedded sections of human breast
Simple Western
Sample: HepG2 human hepatocellular carcinoma cell line
Western Blot
Sample: K562 human chronic myelogenous leukemia cell line and HEK293 human embryonic kidney cell line
Reviewed Applications
Read 1 review rated 4 using AF6810 in the following applications:
Formulation, Preparation, and Storage
Purification
Reconstitution
Formulation
Shipping
Stability & Storage
- 12 months from date of receipt, -20 to -70 °C as supplied.
- 1 month, 2 to 8 °C under sterile conditions after reconstitution.
- 6 months, -20 to -70 °C under sterile conditions after reconstitution.
Background: Cyclin E1
Cyclin E1 (also known as G1/S-specific cyclin-E1 and CCNE1) is a 48-58 kDa member of the cyclin E subfamily, cyclin family of molecules. It associates with Cdk2 kinase, and determines substrate specificity for the complex. This complex phosphorylates multiple substrates involved in cell cycle progression and the initiation of DNA replication. Cyclin E1 is required for G1/S phase progression and cell cycle reentry from G0 phase. Its reduced activity during cellular senescence contributes to G1 arrest. Human cyclin E1 is 410 amino acids (aa) in length. It contains two cyclin box folds (aa 144-234 and 293-363) and is phosphorylated on at least eight Ser/Thr sites. There are at least two alternate splice forms. One is 40-41 kDa in size and utilizes an alternate start site at Met46, while a second is 43-44 kDa in size and shows a deletion of aa 154-196. One other potential start site exists at Met16. There are multiple proteolytic cleavage products that are tumor-associated and show increased destabilizing activity. Cleavage around Gln40 generates 44-45 kDa C-terminal fragments, while cleavage between Ala69Asp70 generates 33-35 kDa C-terminal fragments. Over aa 16-143, human cyclin E1 shares 67% aa identity with mouse cyclin E1.
Alternate Names
Gene Symbol
UniProt
Additional Cyclin E1 Products
Product Documents for Human Cyclin E1 Antibody
Product Specific Notices for Human Cyclin E1 Antibody
For research use only